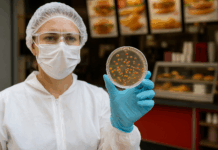

Не сме се виждали, море
и мъката ми е безкрайна.
Едва ли ще го разбереш
това, което пазя в тайна.
Летя, разпъната на кръст,
между житейските дилеми,
а времето препуска в тръс
и сънищата ми отнема.
Навярно днес ми пращащ знак,
че ме позна и се вълнуваш.
Душата ми със теб е пак,
а ти сред звуците ме чуваш.
Сега се срещаме. Напук
на сблъсъци, беди, неволи,
аз пак ще идвам. Ще съм тук
и пак пред тебе ще се моля.